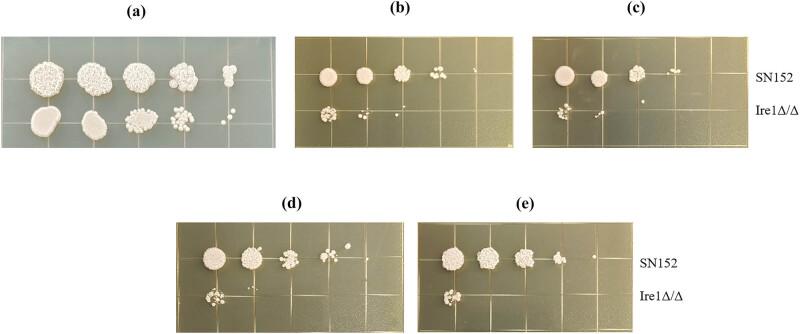

Ire1基因对……的毒力和致病性的影响。 (原文此处不完整,缺少具体对象)
Effects of Ire1 gene on virulence and pathogenicity of .
作者信息
Zhao Huihai, Qin Lixia, Li Mengyan, Jiang Mengyu, Cui Mengge, Wang Hua, Hou Baohua, Wang Fukun, Jia Keran
机构信息
Clinical Laboratory, The 980Th Hospital of PLA Joint Logistical Support Force (Bethune International Peace Hospital), 398 Zhongshan Road, Shijiazhuang, Hebei, 050082, People's Republic of China.
出版信息
Open Life Sci. 2025 Apr 29;20(1):20221062. doi: 10.1515/biol-2022-1062. eCollection 2025.
With the extensive utilization of antifungal drugs, the drug resistance of is progressively intensifying, and the effect of empirical treatment for infection is not evident. There is an urgent need for novel strategies and methods for the treatment of infection. Our study utilized the previously constructed Ire1 double gene deletion strain to explore the influence of the Ire1 on endoplasmic reticulum (ER) stress and pathogenicity of through drug stress phenotype testing, biofilm and hyphomycete formation testing, and mouse systemic infection testing. The results indicate that Ire1 is involved in maintaining the integrity of the cell wall and influencing the hyphal formation ability of . Concurrently, the deletion of the Ire1 increased the sensitivity of to the ER stress agents tunicamycin and dithiothreitol and diminished the biofilm formation ability of , resulting in significant inhibition of the growth of . In mouse models, the deletion of Ire1 completely nullified the virulence and pathogenicity of in the tail vein infection. In conclusion, Ire1 might be a key target for the potential development of new therapeutic drugs and vaccines.
随着抗真菌药物的广泛使用,[具体真菌名称]的耐药性逐渐增强,[具体真菌名称]感染的经验性治疗效果不明显。迫切需要治疗[具体真菌名称]感染的新策略和方法。我们的研究利用先前构建的[具体真菌名称]Ire1双基因缺失菌株,通过药物应激表型测试、生物膜和菌丝体形成测试以及小鼠全身感染测试,探讨Ire1对内质网(ER)应激和[具体真菌名称]致病性的影响。结果表明,Ire1参与维持[具体真菌名称]细胞壁的完整性并影响[具体真菌名称]的菌丝形成能力。同时,Ire1的缺失增加了[具体真菌名称]对ER应激剂衣霉素和二硫苏糖醇的敏感性,并降低了[具体真菌名称]的生物膜形成能力,导致[具体真菌名称]的生长受到显著抑制。在小鼠模型中,Ire1的缺失完全消除了[具体真菌名称]在尾静脉感染中的毒力和致病性。总之,Ire1可能是新型治疗药物和疫苗潜在开发的关键靶点。